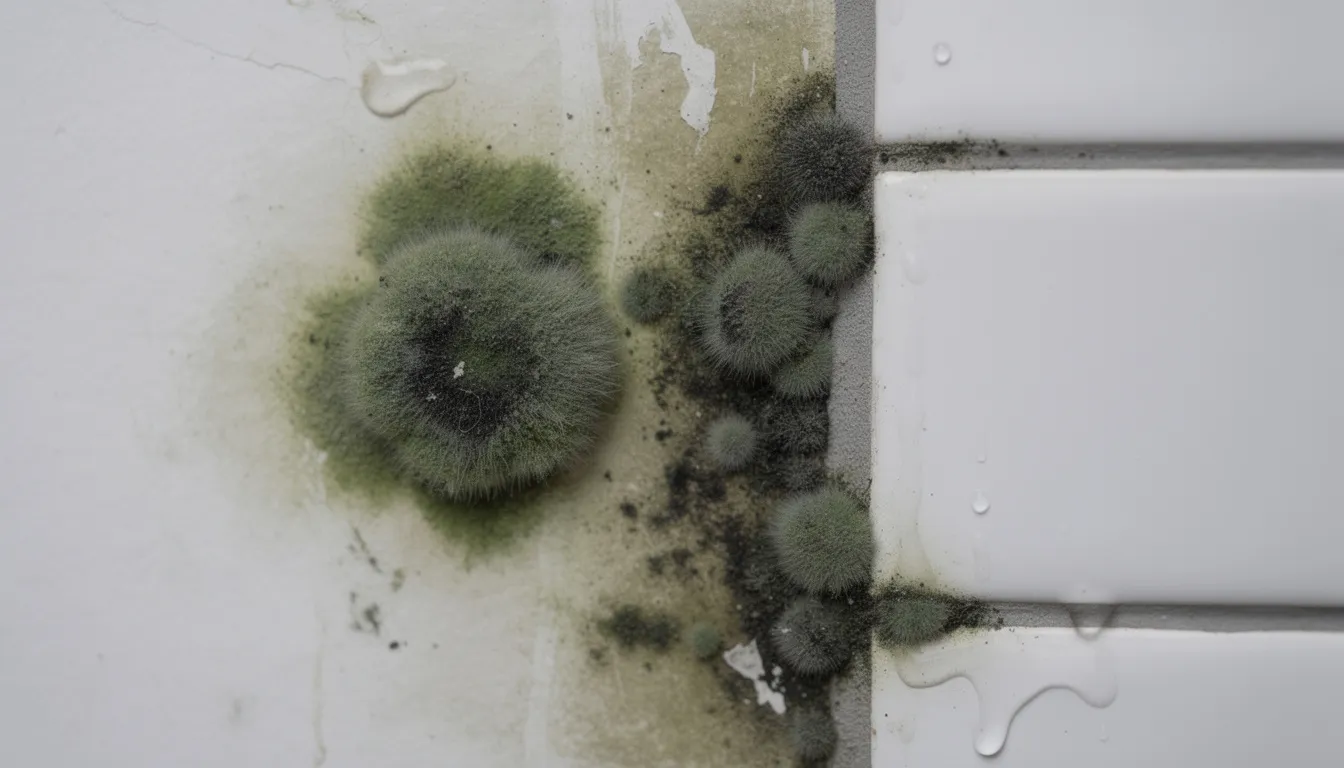
A close-up view of fuzzy green and black mold growing on a damp bathroom wall, particularly near the tile grout, highlights the conditions that facilitate mold growth, such as excess moisture and poor ventilation. This image serves as a reminder of the health hazards posed by mold colonies, which thrive in high humidity environments.

What creates mold? Causes, conditions & ways to stop it

What Creates Mold? Causes, Conditions & Ways to Stop It
Mold isn’t mysterious. It’s not random. And it doesn’t appear out of nowhere. Understanding what creates mold is the first step toward keeping it out of your home—and knowing exactly what to do when you spot the first signs of trouble.
Quick Answer: What Actually Creates Mold?
Mold is created when microscopic mold spores land on a damp surface and remain wet long enough to grow. These spores are always floating in the air, indoors and outdoors, waiting for the right conditions to settle and multiply.
The three essentials that create mold are:
Moisture – Water from leaks, humidity, condensation, or flooding
A food source – Organic material like wood, paper, fabric, drywall, or even dust
The right temperature – Typically between 60°F and 86°F, which matches most indoor environments
Think about where you’ve seen mold before. Bathrooms after hot showers. Basements after heavy rain during 2024 storms. Kitchens with chronic leaks under the sink. These aren’t coincidences—they’re predictable outcomes when moisture meets organic material in a warm space.
Here’s the critical timeline: mold can start growing within 24 to 48 hours after a leak or flood if materials aren’t dried properly. That’s not much time to act.
Outdoor mold is natural and serves an important ecological role—it breaks down dead organic matter like fallen leaves and decaying wood. But indoor mold growth is different. When mold thrives inside your house, it threatens both your health and the structural integrity of your home.
The Science of Mold: What It Is and How It Forms
Mold belongs to a large group of fungi that reproduce by releasing spores into the air continuously throughout the year. Unlike plants, molds don’t need sunlight—they get energy by breaking down organic material around them.
Here’s what you need to know about mold biology:
Mold spores are always present in both indoor and outdoor air and can’t be completely eliminated from any environment
Common indoor genera include Aspergillus (including aspergillus fumigatus), Penicillium, Cladosporium, and Stachybotrys
When spores land on a moist, nutrient-rich surface, they germinate and form thread-like filaments called hyphae
These hyphae spread and interconnect to form visible mold colonies—the fuzzy or slimy patches you actually see
Most molds reproduce and grow best at typical indoor temperatures between 60°F and 86°F. However, some species can grow anywhere from 35°F to 100°F, which means your refrigerator isn’t automatically safe, and neither is your attic in summer.
One important clarification: “toxic mold” isn’t a separate category. The term refers to molds that produce mycotoxins—harmful substances released during growth. Any uncontrolled mold growth indoors is a concern, regardless of whether it’s technically “toxic” or not.
The Mold Growth Triangle: Moisture, Food & Temperature
Think of mold creation like a three-legged stool. Remove any one leg, and the whole thing collapses. Mold requires all three factors—moisture, food, and temperature—present at the same time to flourish.
Moisture is the primary driver. This includes liquid water from leaks, high humidity levels above 60%, or condensation forming on cold surfaces. Without moisture, spores remain dormant indefinitely.
Food means organic material. Mold feeds on cellulose-based materials like the paper facing on drywall from a 1990s home, framing lumber, cardboard boxes, carpets, upholstery, and even household dust. Mold literally digests these materials, breaking them down over time.
Temperature in most North American homes falls perfectly within the range that supports mold. If you’re comfortable, mold probably is too. Temperatures between 70°F and 90°F are ideal for rapid mold growth.
Here’s the practical reality: you can’t remove every food source from your home. Your walls, floors, furniture, and belongings all contain organic material. That’s why controlling moisture—and sometimes temperature—is the most effective prevention strategy.
Time functions as a “silent” fourth factor in this equation. The longer moisture remains on a surface, the more established and destructive mold becomes. A small leak ignored for months causes far more damage than a flood that’s dried within 48 hours.
Major Moisture Sources That Create Mold Indoors
Nearly all problematic indoor mold growth traces back to one or more moisture sources. Case studies from 2020 through 2024 consistently show that finding and fixing the water problem is the key to solving any mold issue.
Plumbing leaks are among the most common culprits. Small, slow leaks behind walls or under sinks often go unnoticed for weeks. Connections around 1990s copper pipes, water heaters, and supply lines gradually fail over time. Even minor drips can saturate drywall and create perfect conditions for mold growing in hidden spaces.
Roof leaks cause extensive damage before you notice them. Damaged shingles, flashing failures around chimneys and skylights, and ice dams in winter all allow water into attic spaces. By the time you see ceiling stains, mold may already be present on roof sheathing and insulation.
Foundation and basement seepage happens when hydrostatic pressure forces water through cracks after heavy storms. Major rain events in 2023 and 2024 saturated soil around countless foundations, pushing dampness through basement walls and floor slabs.
Flooding from river overflows, storm surges, or burst pipes saturates everything it touches. Drywall, insulation, flooring, and furniture can remain wet for days, giving mold colonies ample time to establish.
Condensation forms when warm, humid indoor air contacts cold surfaces. This commonly occurs on poorly insulated exterior walls, single-pane windows, uninsulated metal ducts, and in crawl spaces where temperature differences create moisture.
Appliances frequently contribute to hidden moisture problems. Malfunctioning dishwashers, washing machines, and refrigerators create puddles and leaks. Clogged AC drain lines are particularly problematic—when your air conditioner isn’t draining properly, water backs up and overflows, often into wall cavities or onto flooring.
Everyday activities add surprising amounts of moisture to indoor air. Long hot showers, boiling water while cooking, drying clothes indoors on racks, and even large aquariums all increase indoor humidity without adequate ventilation to compensate.
The critical threshold to remember: any moisture that isn’t fully dried within 24–48 hours can transform a minor incident into active mold growth. Speed matters.

Environmental Conditions That Encourage Mold
Moisture alone doesn’t tell the whole story. Surrounding conditions like relative humidity, ventilation quality, and insulation performance strongly influence whether mold creation occurs.
High Humidity and Poor Ventilation
Relative humidity above 60% indoors, combined with stagnant air, creates an environment conducive to surface mold on walls, ceilings, and furniture—even without visible water leaks. The moisture levels in the air itself become sufficient to feed mold growth.
Typical problem areas include:
Bathrooms without working exhaust fans or with fans that vent into attics instead of outdoors
Laundry rooms where dryers vent poorly or where wet clothes hang to dry
Tightly sealed newer homes without balanced ventilation systems
Any space with limited air circulation where humidity accumulates
Poor ventilation allows humidity to build up over time. Without adequate ventilation and air movement, moisture-laden air becomes trapped, and mold problems become inevitable.
Temperature Patterns
Rooms kept consistently cool and damp present particular challenges. Basements maintained at 60–65°F during spring often develop condensation and mold on concrete, wood framing, and stored items.
Thermal bridges and cold corners on exterior walls create localized condensation spots. Mold frequently appears behind sofas pushed against cold exterior walls, behind wardrobes, and in bedroom corners where furniture blocks airflow.
Insulation and Building Envelope Issues
Missing or compressed insulation—common in 1980s through 2000s construction—causes cold spots behind drywall. These cold spots attract condensation, leading to mold rings and patches that seem to appear from nowhere.
Poorly sealed windows and doors allow moist outdoor air infiltration, especially in rainy or coastal climates. A vapor barrier that’s improperly installed or damaged can trap moisture inside wall cavities, creating hidden mold problems that only become apparent during renovations.
Common Places Mold Develops and Why
Knowing where mold tends to form helps you inspect and act before small problems become major infestations. Certain areas of your home consistently facilitate mold growth due to their moisture exposure and limited ventilation.
Bathrooms and Kitchens
Bathrooms combine steam from showers, frequent splashes, and often inadequate ventilation into a perfect mold habitat. Check these spots regularly:
Shower surrounds and tile grout where moisture penetrates porous surfaces
Silicone caulking around tubs and showers that traps water
Under-sink cabinets where drain lines and supply connections may leak
Around dishwashers and refrigerators where water supply lines connect
Window sills in bathrooms where condensation collects
Kitchens generate humidity from cooking and dishwashing. Combined with the organic residues that accumulate on other surfaces, kitchens offer both moisture and food for mold.
Basements and Crawl Spaces
Basements and crawl spaces rank among the most mold-prone areas in any house:
Unfinished concrete basement walls absorb ground moisture and provide surfaces for mold
Exposed joists and wooden structural elements in crawl spaces stay damp in humid conditions
Stored cardboard boxes and furniture provide readily available food sources
Ground moisture wicks upward through concrete slabs without proper vapor barriers
Poor drainage from gutters directs water toward foundations rather than away
Crawl spaces often lack conditioned air entirely, allowing humidity levels to climb unchecked throughout humid seasons.
Attics
Attic mold typically grows on the underside of roof sheathing, on rafters, and around vent terminations:
Bathroom and kitchen exhaust fans that terminate into the attic rather than outside pump humid air directly onto cold surfaces
Blocked soffit vents prevent adequate air circulation, trapping moisture
Inadequate insulation allows warm, moist interior air to reach cold roof sheathing
Roof leaks introduce liquid water that saturates wood and insulation

Bedrooms and Living Areas
You might not expect mold in main living spaces, but it commonly appears:
Behind heavy furniture pushed against exterior walls where air circulation is blocked
Behind wardrobes and dressers on north-facing cold walls
On window sills where condensation from energy-efficient windows installed in 2020–2024 collects
In closets crammed with clothes against cold walls
The combination of trapped air behind furniture and temperature differences on exterior walls creates localized condensation zones where mold colonies can establish.
Furniture and Belongings
Your possessions can also harbor mold:
Upholstered sofas stored in damp basements absorb moisture from the air
Wooden dressers sitting on wet carpets wick moisture upward
Closet contents packed tightly against cold walls develop mold on fabrics and leather
Engineered wood furniture panels break down when exposed to persistent dampness
Human Habits That Unintentionally Create Mold
Many mold problems aren’t caused by building defects or catastrophic events. Everyday routines often tip conditions from safe to mold-friendly without anyone realizing it.
Common habits that encourage mold growth include:
Ignoring small leaks under sinks, around toilets, or at refrigerator ice-maker lines for weeks or months. That slow drip adds up to significant moisture accumulation.
Drying laundry indoors on racks without using exhaust fans or opening windows. A single load of wet laundry releases liters of water vapor into your home.
Turning off exhaust fans immediately after showering or cooking, or simply not using them at all. Humidity needs time to vent outside.
Pushing furniture against walls without leaving gaps for air circulation, especially against poorly insulated exterior walls.
Overwatering houseplants and allowing water to sit in saucers where it evaporates into the room or spills onto nearby surfaces and floors.
Running humidifiers continuously in winter, pushing indoor humidity above 50–60% in bedrooms and nurseries where windows and walls become condensation traps.
Leaving wet items piled in corners or closets—towels, gym bags, pet bedding, and damp shoes all create localized moisture sources.
Better habits make a significant difference. Run exhaust fans for 20–30 minutes after showers. Keep furniture 1–2 inches away from exterior walls. Fix small leaks the week you notice them, not “eventually.”
Health & Structural Consequences Once Mold Takes Hold
Mold creation isn’t just a cosmetic problem. Once established, mold affects both human health and building integrity in ways that escalate over time.
Health Impacts
Mold exposure causes a range of health effects, particularly affecting respiratory systems:
Nasal congestion, coughing, wheezing, and throat irritation
Eye irritation and skin rashes
Triggered or worsened asthma symptoms
Allergic reactions ranging from mild to severe
People with existing allergies, asthma, or weakened immune systems face heightened risk from indoor mold. Children and older adults are particularly vulnerable. Prolonged exposure can turn a temporary health hazard into chronic health problems.
Structural and Material Damage
Mold doesn’t just sit on surfaces—it actively digests organic material:
Drywall paper delaminates and crumbles as mold consumes the cellulose
OSB sheathing and framing lumber soften, leading to dry rot and structural weakening
Wood framing can reach 20–30% moisture content after leaks, well above the 16% threshold for colonization
Carpets, padding, and insulation become unsalvageable once mold penetrates deeply
During 2022–2024 renovations, contractors frequently discovered subfloor rot around long-term bathroom leaks that homeowners never suspected. What looked like minor water stains on the surface masked serious structural decay underneath.
Economic Consequences
The financial impact of extensive mold and moisture damage includes:
Removal and replacement of walls, flooring, and insulation
Professional mold remediation costs ranging from hundreds to tens of thousands of dollars
Negative impacts on home sale inspections and property values
Insurance claim complications, especially if maintenance neglect contributed to the problem
U.S. homeowners collectively spend billions annually on mold-related repairs and mold testing assessments.
Stopping Mold at the Source: Prevention & Early Action
Since moisture is the controllable factor in the mold equation, prevention focuses on keeping materials dry and maintaining appropriate indoor humidity levels.
Moisture Control
Keep indoor humidity between 30–50% using dehumidifiers and air conditioning—verify levels with an inexpensive hygrometer
Repair plumbing leaks and roof damage promptly, not “when you get around to it”
Dry any wet materials within 24–48 hours using fans, dehumidifiers, and open windows when weather permits
Address condensation issues on windows and cold surfaces by improving insulation or increasing air temperature
Your air conditioner does more than cool—it removes moisture from indoor air. Make sure it’s operating properly and that drain lines are clear and draining correctly.

Ventilation and Airflow
Use exhaust fans in bathrooms and kitchens during and for 20–30 minutes after moisture-generating activities
Ensure dryer vents terminate outdoors, not into attics or crawl spaces
Check that all exhaust systems are working properly and clear of debris
Leave small gaps (1–2 inches) behind furniture against exterior walls
Periodically move furniture and rugs to inspect walls and floors underneath
Open interior doors to promote air circulation throughout your home
Building and Drainage Measures
Maintain gutters and downspouts to direct water away from foundations
Ensure soil grades slope away from your home’s foundation
Seal foundation cracks and consider exterior waterproofing if basement seepage persists
Upgrade insulation in areas where chronic condensation appears, particularly on exterior walls and in attics
Inspect and maintain any vapor barrier in crawl spaces
Cleaning and Maintenance
Vacuum regularly, preferably with HEPA filtration to capture spores and reduce dust that serves as a food source
Clean window tracks, window sills, and HVAC drip pans where moisture and organic debris accumulate
Wipe down shower walls and tubs after use to remove excess moisture
Empty and clean dehumidifier reservoirs and check air conditioner drain lines regularly
When to Call Professionals
Not every mold problem is a DIY project. Contact trained professionals when you encounter:
Mold covering areas larger than approximately 10 square feet
Mold following flooding or sewage backup
Mold inside HVAC systems or affecting ductwork
Mold you can smell but can’t find mold visually
Recurring mold in the same location despite previous cleaning
Any mold issue accompanied by significant structural damage
Professional mold remediation includes air sample testing, containment, HEPA filtration, and proper disposal of contaminated materials—steps that prevent cross-contamination throughout your home completely.
Frequently Asked Questions About What Creates Mold
Can mold grow in my home even if I don’t see any water?
Yes. Mold doesn’t require standing water or visible leaks. High humidity levels above 60%, condensation on cold surfaces, and hidden moisture in wall cavities all provide sufficient dampness for mold spores to germinate and grow. You might have a mold issue without ever noticing a water event.
What temperature range creates the most mold indoors?
Molds play their most active role between 70°F and 90°F—which happens to match typical indoor comfort settings. However, most molds can grow anywhere from about 40°F to 100°F. Temperature alone rarely prevents mold; controlling moisture is far more effective.
How fast does mold grow after a leak or flood?
Mold can begin growing within 24 to 48 hours after materials become wet. This rapid timeline is why immediate drying after any water event is critical. Waiting a week to deal with wet drywall or carpet typically means you’ll find mold already established.
Why does mold keep coming back in the same spot?
Recurring mold almost always indicates an unresolved moisture source. The original water problem—whether a slow leak, condensation issue, or humidity problem—was never fixed. Additionally, if previous cleaning didn’t remove all contaminated materials, remaining mold roots can regrow when moisture returns. Solving the underlying moisture problem is the only permanent fix.
Does opening windows help prevent mold?
It depends on your climate. In dry climates, opening windows increases air circulation and can reduce indoor humidity. However, in humid climates or during rainy seasons, outdoor humidity may be higher than indoor humidity, making the problem worse. Check your local conditions before relying on natural ventilation as a mold prevention strategy.
How many spores are typically in indoor air?
Normal indoor environments contain hundreds to thousands of mold spores per cubic meter of air. This is unavoidable and generally harmless. Problems arise when indoor mold colonies produce spores at rates far exceeding normal background levels, contaminating air throughout the affected area.
Conclusion: Understanding What Creates Mold to Keep It Away
Mold is created whenever airborne spores find moisture, a food source, and the right temperature for long enough to germinate and grow. This happens in homes every day—sometimes visibly in bathrooms and basements, sometimes hidden inside walls or under flooring.
Controlling moisture and indoor humidity is the most effective way to prevent mold growth before it damages your home’s structure or affects your family’s health. The formula is straightforward: eliminate excess moisture, and you eliminate the conditions mold needs to thrive.
Make a habit of inspecting high-risk areas regularly. Check bathrooms, basements, attics, and spaces around windows and HVAC systems—especially those installed or updated since 2020. Act quickly on any signs of water problems: stains, musty odors, peeling paint, or visible dampness.
If you suspect a hidden or recurring mold problem that you can’t locate or resolve yourself, consider a professional moisture and mold assessment rather than hoping it goes away. The cost of investigation is almost always less than the cost of ignoring a problem until it becomes a major remediation project.



